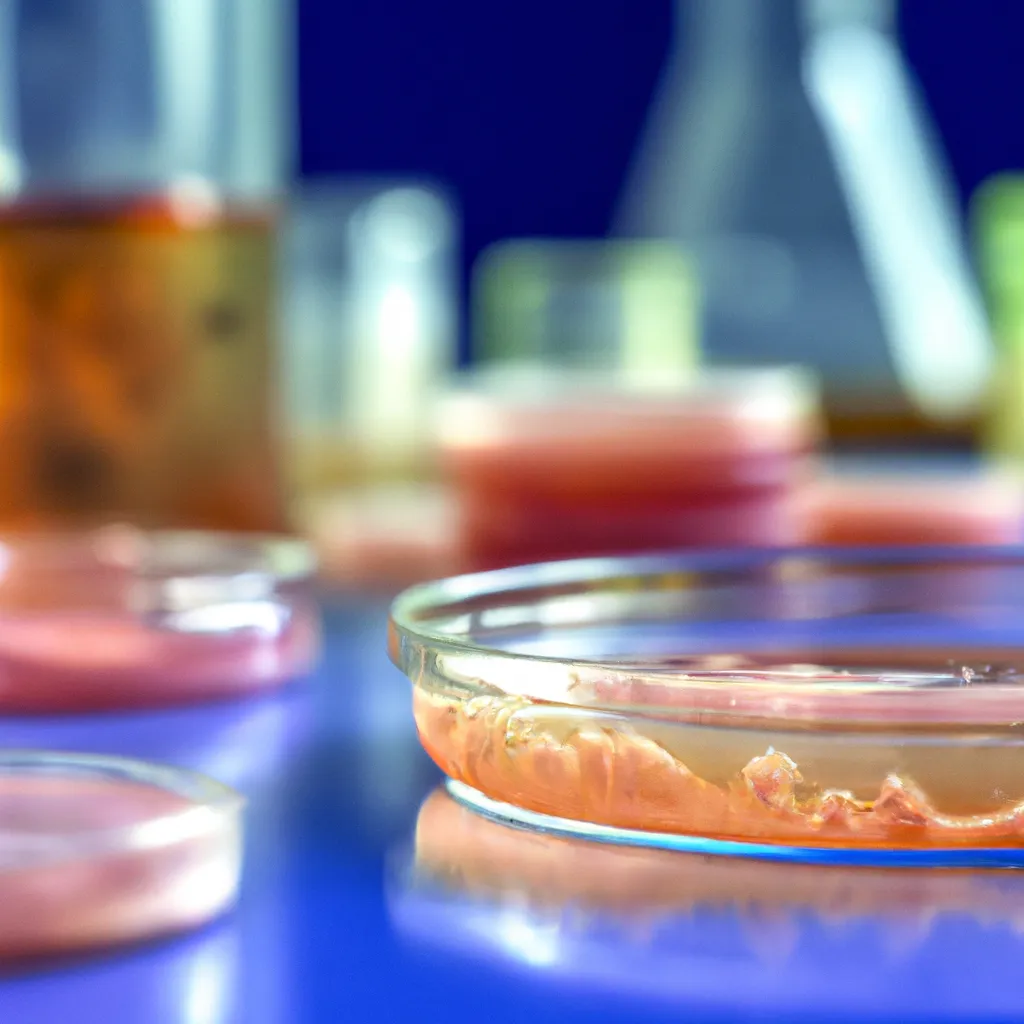

Agar to niezwykle interesująca substancja, której popularność rośnie w różnych dziedzinach – od kulinariów po badania naukowe. Choć kojarzy się głównie z żelatyną roślinną, jego możliwości są znacznie szersze. To właśnie dzięki unikalnym właściwościom i szerokiemu zakresowi zastosowań agar zdobywa coraz większe uznanie. W tym artykule dokładnie przyjrzymy się, co to jest agar, jakie ma właściwości oraz gdzie jest stosowany.
Co to jest agar?
Agar jest polisacharydem otrzymywanym z czerwonych alg morskich, szczególnie z gatunków takich jak Gelidium i Gracilaria. Substancja ta jest szeroko stosowana jako środek żelujący, stabilizujący i zagęszczający. W przeciwieństwie do żelatyny, która jest pochodzenia zwierzęcego, agar jest produktom roślinnym, co czyni go idealnym dla wegan i wegetarian oraz dla osób nietolerujących laktozy. Pierwsze doniesienia o użyciu agaru pochodzą z Japonii, gdzie był znany jako „kanten” i używany zarówno w kuchni, jak i w medycynie tradycyjnej.
Agar znajduje się w formie proszku, płatków lub prętów i charakteryzuje się wyjątkową zdolnością do tworzenia stabilnych żeli w niskich temperaturach. To sprawia, że jest on niezwykle wszechstronny i znajduje zastosowanie w wielu różnych dziedzinach. Agaryna, czyli forma agaru w postaci żelu, jest odporniejsza na degradację w wyższych temperaturach w porównaniu z żelatyną, co jest kolejnym atutem tej substancji.
Właściwości agaru
Agar wykazuje szereg unikalnych właściwości, które sprawiają, że jest niezastąpiony w wielu dziedzinach. Jedną z kluczowych cech agaru jest jego zdolność do tworzenia żelu w temperaturach od 32 do 40 stopni Celsjusza i pozostawania stabilnym do temperatury około 85 stopni Celsjusza. To powoduje, że agar jest bardziej termostabilny niż inne środki żelujące. Dodatkowo, agar jest rozpuszczalny tylko w gorącej wodzie i tworzy silne, przezroczyste żele, które są niewrażliwe na kwaśne środowisko.
Niezwykle ważnym aspektem agaru jest jego wysoka zawartość błonnika, która stanowi aż około 80% jego masy. To sprawia, że agar jest ceniony nie tylko jako środek żelujący, ale także jako suplement diety poprawiający perystaltykę jelit. Ponadto, agar praktycznie nie zawiera kalorii, dzięki czemu jest idealny dla osób na diecie niskokalorycznej. Warto dodać, że agar jest bezwonny i bezbarwny, co sprawia, że nie wpływa na smak i wygląd przygotowywanych potraw.
Agar ma także zastosowania zdrowotne: wspomaga trawienie, przyczynia się do detoksykacji organizmu i może działać jako łagodny środek przeczyszczający. Ma szerokie działanie prebiotyczne, wspierając zdrową florę bakteryjną jelit. A ponieważ jest roślinny, może być stosowany przez osoby z różnymi ograniczeniami dietetycznymi, w tym wegan i wegetarian.
Zastosowania w kuchni
Agar zyskał dużą popularność w kuchniach na całym świecie, szczególnie w przemyśle cukierniczym i gastronomicznym. Jest wykorzystywany do przygotowania deserów, żelów owocowych, galaretek, dżemów i różnych rodzajów kremów. Ze względu na swoje wyjątkowe właściwości żelujące, znajduje zastosowanie w wegańskich i wegetariańskich przepisach, zastępując tradycyjną żelatynę. W kuchni molekularnej agar używany jest do tworzenia efektownych przygotowań kulinarnych, takich jak sferyfikacja czy tworzenie żelowych kapsułek.
Ponadto agar jest także niezastąpionym składnikiem różnych napojów i koktajli, nadając im niepowtarzalną konsystencję i stabilność. Jednym z popularnych napojów zawierających agar jest bubble tea, gdzie jest używany do wytwarzania charakterystycznych kulek boba. Dzięki temu napoje z agarowym dodatkiem stają się bardziej atrakcyjne wizualnie i ciekawsze pod względem tekstury.
W kuchni azjatyckiej agar jest stosowany jako składnik tradycyjnych potraw, takich jak japońskie desery anmitsu czy tajwański aiyu jelly. Jego wszechstronność sprawia, że agar może być dodawany do zup, sałatek i dań głównych jako zagęstnik, stabilizator lub środek żelujący. Warto także dodać, że agar jest odporny na kwasy, co oznacza, że może być używany w potrawach zawierających owoce cytrusowe, ocet czy inne składniki o kwasowym odczynie.
Zastosowania w laboratoriach
Laboratoria naukowe na całym świecie od dawna wykorzystują agar ze względu na jego doskonałe właściwości żelujące. Jest szeroko stosowany w mikrobiologii jako medium hodowlane dla bakterii i grzybów. Agar jest dodawany do pożywek, takich jak Agar LB (Luria-Bertani), Agar Tryptsojowy czy Agar Sabouraud, które są podstawowymi narzędziami w badaniach mikrobiologicznych. Dzięki zdolności do tworzenia stabilnych żeli, agar umożliwia łatwe oddzielanie i identyfikowanie różnych mikroorganizmów.
Kolejnym istotnym zastosowaniem agaru w laboratoriach jest mikrobiologiczne testowanie antybiotyków. Metoda dyfuzji krążkowej, znana jako metoda Kirby’ego-Bauera, wykorzystuje agar do testowania wrażliwości bakterii na różne antybiotyki. Agar jest tu nieodzowny, ponieważ tworzy jednolitą, stabilną powierzchnię, na której można precyzyjnie nanosić dyski z antybiotykami.
Agar jest także wykorzystywany w badaniach biotechnologicznych i genetycznych. Jest używany jako nośnik w technikach elektroforeza żelowa, gdzie umożliwia rozdzielanie i analizowanie fragmentów DNA, RNA i białek pod wpływem pola elektrycznego. Jest to narzędzie niezwykle ważne w badaniach nad genomiką, proteomiką i różnymi dziedzinami inżynierii genetycznej.
Dzięki swoim neutralnym właściwościom chemicznym, agar nie wchodzi w interakcje z większością substancji chemicznych, co sprawia, że jest idealnym materiałem do różnych eksperymentów laboratoryjnych. Jest także nietoksyczny i biologicznie obojętny, co czyni go bezpiecznym dla organizmów badawczych i personelu laboratorium. Wreszcie, agar jest łatwo dostępny i stosunkowo tani, co czyni go atrakcyjnym wyborem dla wielu zastosowań naukowych.